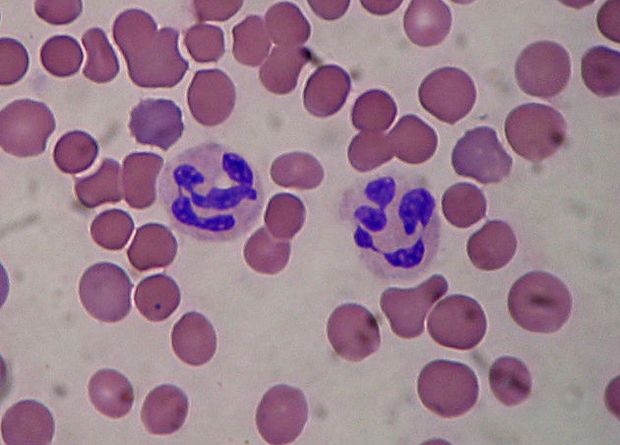

Дефицит тестостерона помешал лейкоцитам справиться с меланомой
Американские ученые в результате экспериментов на мышах, склонных к развитию меланомы, обнаружили, что стерилизация самок не оказывает влияния на рост опухолей, а вот кастрация самцов повышает количество опухолевых очагов в несколько раз. Судя по всему, виноваты иммунные клетки нейтрофилы, а также тестостерон — по крайней мере, его инъекция этот эффект нейтрализует. Этот же механизм может объяснить, почему пожилые мужчины болеют меланомой чаще, чем женщины, а также может помочь придумать более эффективную терапию для рака простаты. Работа опубликована в журнале Nature Communications.
Одна из самых опасных опухолей человека — меланома — встречается в популяции неравномерно. Ее распространенность почти не отличается у мужчин и женщин до 50 лет, но после 50 мужчины начинают ей болеть почти в два раза чаще, чем женщины. Более того, пол является важным фактором для прогноза развития опухоли вне зависимости от прочих условий — размера, расположения на теле, степени снабжения сосудами и так далее. Однако до сих пор неясно, как именно пол может быть связан с развитием опухоли, которая не имеет прямого отношения к половым железам.
Дженет Маркмен (Janet Markman) и ее коллеги из Медицинского центра Седарс-Синай в Лос-Анджелесе предположили, что связующим звеном может оказаться активность иммунной системы. Известно, что ее во многих отношениях регулируют половые гормоны: например, эстрогены подавляют воспаление, а андрогены стимулируют заживление ран. Вероятно, и противоопухолевая активность иммунитета тоже регулируется по-разному у мужчин и женщин.